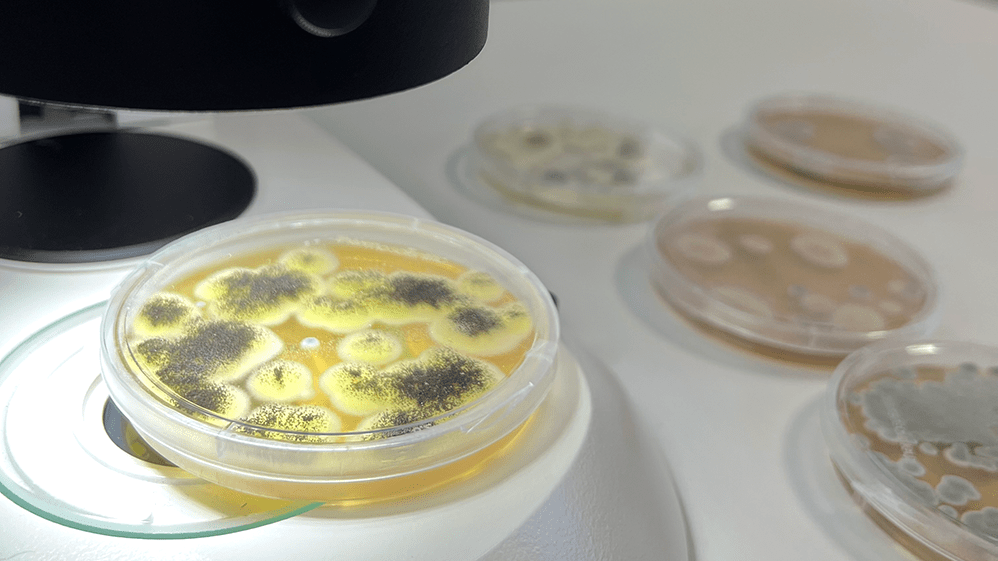
Schimmelanalyse Mikroskop

Schimmel I Bakterien I Allergene
Schimmelanalyse & Bewertung
Schimmel zeigt sich nicht immer dort, wo er entsteht und oft bleibt er lange unbemerkt. Sichtbar wird er erst durch dunkle Verfärbungen, muffigen Geruch oder durch gesundheitliche Symptome wie Husten, Reizungen der Schleimhäute oder Asthma.
Meine Leistungen im Überblick
Alle Leistungen können flexibel kombiniert oder einzeln gebucht werden.
Preisbeispiele
Die folgenden Preise sind Beispiele zur Orientierung. Der tatsächliche Aufwand hängt von der Fragestellung und dem Untersuchungsumfang ab. Häufig lassen sich mehrere Untersuchungen sinnvoll kombinieren, wodurch sich gegenüber einzelnen Terminen andere Preise ergeben können. Gerne erstelle ich ein individuelles Angebot.
Schimmelpilz Check
365 €Nicht jedes Schimmelproblem ist sichtbar. Der Schimmelpilz-Check untersucht auffällige Hinweise und Rahmenbedingungen, die auf Feuchte- oder Schimmelprobleme hindeuten können.
Inklusive
Sichtbarer Schimmelbefall
695 €Sichtbarer Schimmel bedeutet nicht automatisch, dass das gesamte Ausmaß des Problems erkennbar ist. Die Untersuchung hilft dabei, Ursachen, Ausdehnung und erforderliche Maßnahmen besser einzuschätzen.
Inklusive
Raumluftproben
845 €Raumluftproben können Hinweise auf verdeckte Schimmelprobleme liefern. Sie kommen häufig zum Einsatz, wenn Beschwerden bestehen, Schimmel vermutet wird oder nach einer Sanierung überprüft werden soll, ob weiterhin Auffälligkeiten vorliegen.
Inklusive
Meine Messmethoden
Je nach Art und Ausprägung eines Schimmelverdachts oder sichtbaren Befalls sowie unter Berücksichtigung der baulichen Rahmenbedingungen kommen unterschiedliche Probenahmeverfahren zum Einsatz. Ob Luft-, Oberflächen- oder Materialproben – die Auswahl der geeigneten Methode richtet sich nach dem konkreten Untersuchungsziel, dem Schadensbild und den Bedingungen vor Ort.
KLIMADATEN UND FEUCHTEMESSUNGEN
Die Erfassung von Raumklima, Oberflächentemperaturen und Feuchtewerten liefert wichtige Hinweise auf mögliche Feuchtigkeitsprobleme und Schimmelrisiken. Die Messergebnisse helfen dabei, Auffälligkeiten zu erkennen und die Raumsituation besser einzuschätzen.
Bauforensik
Verdeckter Schimmelbefall ist häufig nicht sofort sichtbar. Durch den Einsatz spezieller Lichtquellen und bauforensischer Untersuchungsmethoden lassen sich Auffälligkeiten erkennen und verdächtige Bereiche gezielt untersuchen. Durch die Betrachtung von Schadensbildern, Feuchteverhältnissen und baulichen Zusammenhängen können mögliche Ursachen besser verstanden und gezielte Lösungen entwickelt werden.
Oberflächenproben (Folienkontakt-, Wisch- oder Abklatschproben)
Wenn Schimmel sichtbar oder bauforensisch nachweisbar ist, kann die betroffene Stelle gezielt beprobt werden. Je nach Situation kommen Folienkontaktproben oder sterile Tupfer zum Einsatz. Die Laboranalyse ermöglicht eine Bestimmung der vorhandenen Schimmelpilzarten.
Luftproben (Schimmelsporen und Bakterien in der Raumluft)
Luftproben ermöglichen die Untersuchung der Raumluft auf Schimmelsporen und andere mikrobiologische Belastungen. Die Laboranalyse liefert Informationen über Art und Konzentration der vorhandenen Sporen und unterstützt die Beurteilung der Raumsituation.
Materialproben
Materialproben kommen zum Einsatz, wenn ein tieferliegender Schimmelbefall vermutet wird – beispielsweise nach Wasserschäden, bei überstrichenen Flächen oder in verbauten Bauteilen wie Dämmstoffen. Sie ermöglichen eine gezielte Untersuchung direkt im betroffenen Material.

Ablauf
Kontaktaufnahme
Anruf, E-Mail oder Buchung eines Erstgesprächs.
Erstgespräch
Besprechung der individuellen Anforderungen, Ziele und Messverfahren.
Termin
Begehung der betroffenen Räume, Sichtprüfung und Probenahme mit geeigneter Messtechnik.
Laborauswertung und Analyse
Laboruntersuchung der Proben zur Bestimmung der Art des Schimmels und Belastung.
Abschluss
Schriftlicher Bericht mit Ergebnissen, Bewertung und konkreten Handlungsempfehlungen.
Kundenbewertungen
Sie sehen gerade einen Platzhalterinhalt von TrustIndex. Um auf den eigentlichen Inhalt zuzugreifen, klicken Sie auf die Schaltfläche unten. Bitte beachten Sie, dass dabei Daten an Drittanbieter weitergegeben werden.
Mehr Informationen